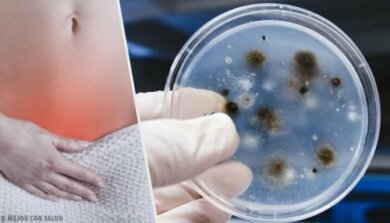
Infezioni vaginali: come riconoscere tipi e cause

Infezioni vaginali: come riconoscere tipi e cause
Le infezioni vaginali sono uno dei motivi principali per cui molte donne si rivolgono al ginecologo. Anche se nella maggior parte dei casi uno dei fattori principali è l’igiene intima, non è l’unico aspetto di cui tenere conto.
Ogni infezione vaginale è causata da un microrganismo specifico. Ad esempio, nel caso della vaginosi batterica gli agenti patogeni saranno i batteri, così come indica il nome. Invece, nel caso della candidosi, l’infezione dipenderà da lieviti.
Nelle prossime righe vi parleremo in dettagli dei tipi di infezione vaginale conosciute, delle rispettive cause e dei sintomi principali.
Gli squilibri nella flora vaginale
All’interno della vagina convivono un insieme di microrganismi che aiutano a proteggerla da agenti patogeni e, quindi, dalle infezioni. Questa popolazione prende il nome di microbiota o flora vaginale.
Ora, quando l’equilibrio della flora vaginale subisce un’alterazione, la donna prova prurito, bruciore, arrossamento e gonfiore alla vulva, oltre ad alterazioni del flusso vaginale, oltre ad altri disturbi.

Principali cause di infezione vaginale
Gli esperti del Young Women’s Health ritengono che le principali cause di infezione vaginale siano:
- Tricomoniasi.
- Vaginosi batterica.
- Infezione da funghi.
Inoltre, sostengono che “tra le cause possono esserci malattie a trasmissione sessuale, un assorbente interno dimenticato all’interno, un problema congenito di vagine o utero, una forma di allergia o di irritazione dovuto all’uso di determinati prodotti come ad esempio i detergenti”.
Per quanto riguarda le infezioni di origine batterica, gli esperti di SaludSexual spiegano che le infezioni batteriche del tratto genitale più comuni sono quelle polimicrobiche (ovvero, quelle alle quali partecipano diversi tipi di germi).
Queste provocano un’alterazione del flusso, dolore pubico, e, se non trattate in tempo e nel modo corretto, possono persino provocare altri problemi più gravi, come sterilità e aumento del rischio di gravidanza extrauterina.
Anche se la maggior parte delle infezioni vaginali hanno dei sintomi in comune, ciascuna di esse si manifesta con una serie di segnali specifici. Per questo motivo non possono essere trattate allo stesso modo.
Tipi di infezioni vaginali e rispettive cause
Tra le infezioni vaginali più comuni, troviamo le seguenti:
1. Candidosi vaginale

A causarla è il fungo Candida albicans. Provoca sintomi quali flusso vaginale abbondante e di colore bianco, oltre a prurito e bruciore, soprattutto durante i rapporti sessuali.
2. Vaginosi batterica
Come spiega il Manuale MSD la vaginosi batterica è dovuta all’alterazione dell’equilibrio batterico vaginale. Si tratta dell’infezione vaginale più frequente e sulla comparsa influiscono fattori quali:
- Avere diversi partner sessuali.
- Utilizzare un dispositivo intrauterino (IUD).
- Essere affette da una malattia trasmissibile sessualmente.
Il sintomo più caratteristico di questa malattia è l’alterazione del flusso vaginale. La secrezione è di colore grigio (o bianco), abbondante e filamentosa, oltre che malodorante (odore di pesce).
Per saperne di più: Curare la vaginosi batterica: 5 consigli
3. Vaginite da Trichomonas (o Tricomoniasi)
È causata da un parassita, un protozoo chiamato Trichomonas Vaginalis, trasmesso attraverso il rapporto sessuale.
Si presenta con secrezioni vaginali molto caratteristiche, di colore verde o giallo, a volte abbondanti e dall’odore forte simile al pesce. Inoltre, è accompagnata da prurito e irritazione. Provoca anche fastidi durante la minzione.
4. La clamidia
Il microrganismo che provoca questo tipo di infezione vaginale è un batterio, la Chlamydia Trachomatis, che si trasmette sessualmente.
Questa malattia può anche essere asintomatica, ma resta ad alto rischio poiché causa micro-lesioni al collo dell’utero che si possono ripercuotere sulla capacità di avere figli. Per questo motivo, trattarla in modo corretto è davvero importante.
Potrebbe interessarvi: Consigli di igiene prima e dopo il sesso orale
Prima si inizia con la terapia meglio è
In conclusione, tutte le infezioni vaginali richiedono un trattamento immediato, per le complicazioni che potrebbero causare a lungo andare, oltre che per le conseguenze sulla qualità della vita.
Se avvertite uno di questi sintomi, quindi, non esitate ad andare al più presto dal medico, in modo da sottoporvi a una valutazione e per cominciare subito il trattamento più indicato.
Le infezioni vaginali sono uno dei motivi principali per cui molte donne si rivolgono al ginecologo. Anche se nella maggior parte dei casi uno dei fattori principali è l’igiene intima, non è l’unico aspetto di cui tenere conto.
Ogni infezione vaginale è causata da un microrganismo specifico. Ad esempio, nel caso della vaginosi batterica gli agenti patogeni saranno i batteri, così come indica il nome. Invece, nel caso della candidosi, l’infezione dipenderà da lieviti.
Nelle prossime righe vi parleremo in dettagli dei tipi di infezione vaginale conosciute, delle rispettive cause e dei sintomi principali.
Gli squilibri nella flora vaginale
All’interno della vagina convivono un insieme di microrganismi che aiutano a proteggerla da agenti patogeni e, quindi, dalle infezioni. Questa popolazione prende il nome di microbiota o flora vaginale.
Ora, quando l’equilibrio della flora vaginale subisce un’alterazione, la donna prova prurito, bruciore, arrossamento e gonfiore alla vulva, oltre ad alterazioni del flusso vaginale, oltre ad altri disturbi.

Principali cause di infezione vaginale
Gli esperti del Young Women’s Health ritengono che le principali cause di infezione vaginale siano:
- Tricomoniasi.
- Vaginosi batterica.
- Infezione da funghi.
Inoltre, sostengono che “tra le cause possono esserci malattie a trasmissione sessuale, un assorbente interno dimenticato all’interno, un problema congenito di vagine o utero, una forma di allergia o di irritazione dovuto all’uso di determinati prodotti come ad esempio i detergenti”.
Per quanto riguarda le infezioni di origine batterica, gli esperti di SaludSexual spiegano che le infezioni batteriche del tratto genitale più comuni sono quelle polimicrobiche (ovvero, quelle alle quali partecipano diversi tipi di germi).
Queste provocano un’alterazione del flusso, dolore pubico, e, se non trattate in tempo e nel modo corretto, possono persino provocare altri problemi più gravi, come sterilità e aumento del rischio di gravidanza extrauterina.
Anche se la maggior parte delle infezioni vaginali hanno dei sintomi in comune, ciascuna di esse si manifesta con una serie di segnali specifici. Per questo motivo non possono essere trattate allo stesso modo.
Tipi di infezioni vaginali e rispettive cause
Tra le infezioni vaginali più comuni, troviamo le seguenti:
1. Candidosi vaginale

A causarla è il fungo Candida albicans. Provoca sintomi quali flusso vaginale abbondante e di colore bianco, oltre a prurito e bruciore, soprattutto durante i rapporti sessuali.
2. Vaginosi batterica
Come spiega il Manuale MSD la vaginosi batterica è dovuta all’alterazione dell’equilibrio batterico vaginale. Si tratta dell’infezione vaginale più frequente e sulla comparsa influiscono fattori quali:
- Avere diversi partner sessuali.
- Utilizzare un dispositivo intrauterino (IUD).
- Essere affette da una malattia trasmissibile sessualmente.
Il sintomo più caratteristico di questa malattia è l’alterazione del flusso vaginale. La secrezione è di colore grigio (o bianco), abbondante e filamentosa, oltre che malodorante (odore di pesce).
Per saperne di più: Curare la vaginosi batterica: 5 consigli
3. Vaginite da Trichomonas (o Tricomoniasi)
È causata da un parassita, un protozoo chiamato Trichomonas Vaginalis, trasmesso attraverso il rapporto sessuale.
Si presenta con secrezioni vaginali molto caratteristiche, di colore verde o giallo, a volte abbondanti e dall’odore forte simile al pesce. Inoltre, è accompagnata da prurito e irritazione. Provoca anche fastidi durante la minzione.
4. La clamidia
Il microrganismo che provoca questo tipo di infezione vaginale è un batterio, la Chlamydia Trachomatis, che si trasmette sessualmente.
Questa malattia può anche essere asintomatica, ma resta ad alto rischio poiché causa micro-lesioni al collo dell’utero che si possono ripercuotere sulla capacità di avere figli. Per questo motivo, trattarla in modo corretto è davvero importante.
Potrebbe interessarvi: Consigli di igiene prima e dopo il sesso orale
Prima si inizia con la terapia meglio è
In conclusione, tutte le infezioni vaginali richiedono un trattamento immediato, per le complicazioni che potrebbero causare a lungo andare, oltre che per le conseguenze sulla qualità della vita.
Se avvertite uno di questi sintomi, quindi, non esitate ad andare al più presto dal medico, in modo da sottoporvi a una valutazione e per cominciare subito il trattamento più indicato.
Tutte le fonti citate sono state esaminate a fondo dal nostro team per garantirne la qualità, l'affidabilità, l'attualità e la validità. La bibliografia di questo articolo è stata considerata affidabile e di precisione accademica o scientifica.
- White, B. A., Creedon, D. J., Nelson, K. E., & Wilson, B. A. (2011). The vaginal microbiome in health and disease. Trends in Endocrinology and Metabolism. https://doi.org/10.1016/j.tem.2011.06.001
- Mashburn, J. (2012). Vaginal Infections Update. Journal of Midwifery and Women’s Health. https://doi.org/10.1111/j.1542-2011.2012.00246.x
- Hainer, B. L., & Gibson, M. V. (2011). Vaginitis: Diagnosis and treatment. American Family Physician. https://doi.org/10.2165/00003495-197204050-00004
- Gonçalves, B., Ferreira, C., Alves, C. T., Henriques, M., Azeredo, J., & Silva, S. (2016). Vulvovaginal candidiasis: Epidemiology, microbiology and risk factors. Critical Reviews in Microbiology. https://doi.org/10.3109/1040841X.2015.1091805
- Malhotra, M., Sood, S., Mukherjee, A., Muralidhar, S., & Bala, M. (2013). Genital Chlamydia trachomatis: an update. The Indian Journal of Medical Research.
Questo testo è fornito solo a scopo informativo e non sostituisce la consultazione con un professionista. In caso di dubbi, consulta il tuo specialista.







